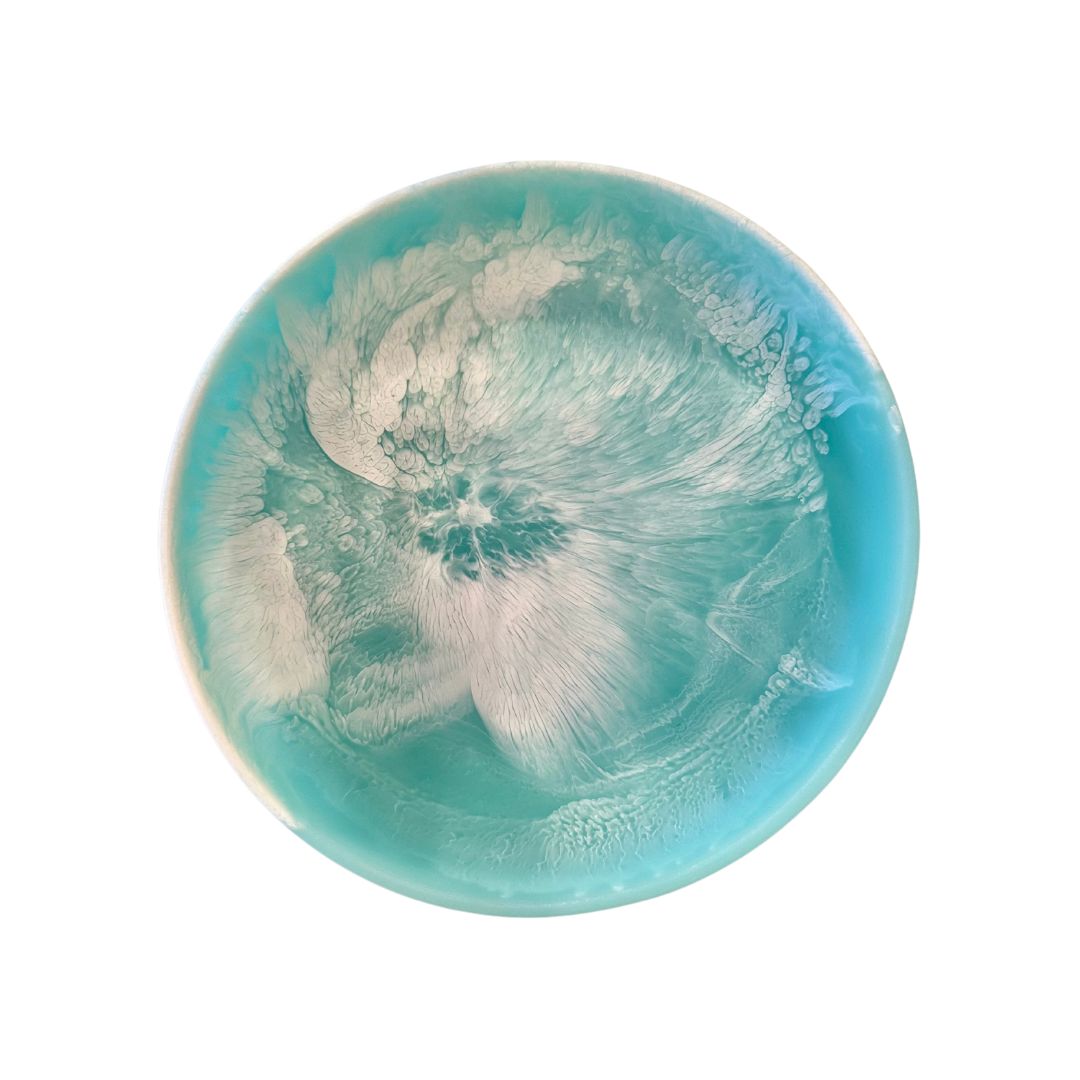

Small Round Platter | Turquoise Swirl
Round Platter Small
Dimensions: 11.8X11.8X1 Inches
Weight: 3 lbs
(Sizing and weight might vary slightly)
All our products are designed in unique shapes and sizes that are easy to mix and match for home decor and everyday entertaining.
BPA Free
Lead Free
Non Porous
FDA Approved- Food Safe
Shatter Resistant
Easy to Clean
All our products are hand crafted. Each piece is individually poured. Making every piece unique. While we aim to have every colour , shape and size consistent please understand that due to the nature of the material slight variation in colour may occur.
Shipping
- Standard shipping $9.95 Australia Wide
- Standard international $35.00
- Free Australia wide shipping for orders over $200
- Express shipping available $20.00 (AU)
- Same day delivery available
Returns
We value each and everyone of our Rose St customers and want you to be happy with your purchase.
Online Purchases
We accept returns 14days from date of delivery with the following conditions:
For a refund we must be notified within 2 days of delivery and email us for a RA Number at returns@rosesttradingco.com.au
- All other returns within the 14 days period will receive a store credit
Items purchased durning a temporary promotion are eligible for a store credit - All Sale items are FInal Sale
- Items must be returned in their original condition and packaging, unworn, unwashed and with all tags attached
In Store Purchases
We offer Store Credit for change of mind purchases within 14 days of date of purchase
Love something that’s currently sold out? Don’t worry — we’ve got you! For restockable items, just click the “Notify Me” button on the product page (below the sold out button).
Enter your email or phone number, and we’ll send you an alert the moment it’s back in stock, along with a direct link to purchase from our website. No need to keep checking back — we’ll make sure you’re the first to know!